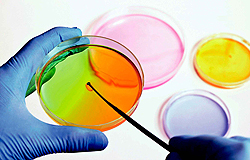
conicet

Por CONICET
El logro de la inocuidad de los alimentos como medio para proteger la salud pública y promover el desarrollo económico continúa siendo un importante desafío en los países tanto en desarrollo como desarrollados. Las enfermedades transmitidas por los alimentos (ETA) como consecuencia de patógenos microbianos y contaminantes químicos representan graves amenazas para la salud de millones de personas. En los pasados decenios se han documentado graves brotes de ETA en todos los continentes, lo que demuestra su importancia desde el punto de vista social y de salud pública.
La integración y concentración de los sectores alimentarios y la globalización del comercio de alimentos están cambiando las pautas para su producción y distribución. Los productos destinados a la alimentación humana y animal llegan hasta lugares mucho más distantes que en el pasado, lo que crea las condiciones necesarias para la difusión de ETA.
 Hasta hace poco tiempo, la mayoría de los sistemas tendientes a regular la inocuidad de los alimentos se basaban en definiciones legales de alimentos no inocuos, programas de cumplimiento de normas para retirar del mercado estos alimentos y sancionar a las partes responsables después de los hechos. Estos sistemas tradicionales no son capaces de responder a los nuevos desafíos existentes y emergentes para la seguridad de los alimentos debido a que no brindan ni estimulan un enfoque preventivo.
Hasta hace poco tiempo, la mayoría de los sistemas tendientes a regular la inocuidad de los alimentos se basaban en definiciones legales de alimentos no inocuos, programas de cumplimiento de normas para retirar del mercado estos alimentos y sancionar a las partes responsables después de los hechos. Estos sistemas tradicionales no son capaces de responder a los nuevos desafíos existentes y emergentes para la seguridad de los alimentos debido a que no brindan ni estimulan un enfoque preventivo.
Como alternativa al enfoque anterior, se produjo durante la última década, una transición hacia el análisis de riesgo, el cual está basado en un mejor conocimiento científico de las ETA y sus causas.
El análisis de riesgo es un proceso estructurado y sistemático mediante el cual se examinan los posibles efectos nocivos para la salud como consecuencia de un peligro presente en un alimento o de una propiedad de éste, y se establecen opciones para mitigar esos riesgos. Este enfoque brinda una base de prevención para las medidas regulatorias dirigidas a la inocuidad de los alimentos tanto a nivel nacional como internacional.
 Conocer las cadenas agroalimentarias y los factores de riesgo que potencialmente impactan sobre la presencia de un peligro en un alimento son factores fundamentales requeridos para sustentar científicamente las medidas de gestión del riesgo. En este sentido, el análisis de riesgo se ha convertido en la piedra angular para el establecimiento de esas medidas, ofreciendo un marco para evaluar, gestionar y comunicar eficazmente los riesgos en colaboración con las diversas partes interesadas y aumenta la capacidad de las autoridades regulatorias para elaborar programas de control o erradicación de enfermedades basados en principios científicos.
Conocer las cadenas agroalimentarias y los factores de riesgo que potencialmente impactan sobre la presencia de un peligro en un alimento son factores fundamentales requeridos para sustentar científicamente las medidas de gestión del riesgo. En este sentido, el análisis de riesgo se ha convertido en la piedra angular para el establecimiento de esas medidas, ofreciendo un marco para evaluar, gestionar y comunicar eficazmente los riesgos en colaboración con las diversas partes interesadas y aumenta la capacidad de las autoridades regulatorias para elaborar programas de control o erradicación de enfermedades basados en principios científicos.
 Un aspecto crítico del análisis de riesgo es la existencia de una separación funcional entre los evaluadores del riesgo y los gestores del riesgo. Lo anterior es necesario si se desea garantizar la independencia de los preceptos eminentemente científicos (evaluación de riesgo) de las políticas y valores considerados por los aspectos regulatorios (gestores del riesgo). No obstante, tratar de hallar un límite claro entre ambas tareas no suele ser sencillo. Esta separación puede ser materializada cuando existen diferentes dependencias encargadas de la evaluación y manejo del riesgo. Esta separación no implica la ausencia total comunicación entre ambos grupos, aspecto vital y necesario en todo proceso de evaluación del riesgo, sino que los evaluadores de riesgo no antepongan otros criterios diferentes a los eminentemente científicos en sus evaluaciones.
Un aspecto crítico del análisis de riesgo es la existencia de una separación funcional entre los evaluadores del riesgo y los gestores del riesgo. Lo anterior es necesario si se desea garantizar la independencia de los preceptos eminentemente científicos (evaluación de riesgo) de las políticas y valores considerados por los aspectos regulatorios (gestores del riesgo). No obstante, tratar de hallar un límite claro entre ambas tareas no suele ser sencillo. Esta separación puede ser materializada cuando existen diferentes dependencias encargadas de la evaluación y manejo del riesgo. Esta separación no implica la ausencia total comunicación entre ambos grupos, aspecto vital y necesario en todo proceso de evaluación del riesgo, sino que los evaluadores de riesgo no antepongan otros criterios diferentes a los eminentemente científicos en sus evaluaciones.